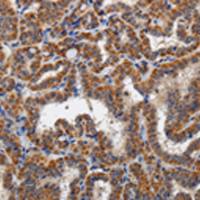
兔抗KLK6多克隆抗体

万千商家帮你免费找货
0 人在求购买到急需产品
- 详细信息
- 文献和实验
- 技术资料
- 抗体名:
TRAK1 抗原(重组蛋白)
- 抗体英文名:
TRAK1 Antigen (Recombinant Protein)
- 应用范围:
仅供科研实验研究
- 供应商:
上海酶联生物科技有限公司
- 库存:
60
- 保质期:
1年
- 适应物种:
动物
- 保存条件:
冷冻(-20℃)
- 形态:
液体
- 规格:
100ug
中文名称 :TRAK1 抗原(重组蛋白)
英文名称 :TRAK1 Antigen (Recombinant Protein)
别 名:trafficking protein, kinesin binding 1; MILT1; OIP106
储 存:冷冻(-20℃)
相关类别 : 抗原
概述
酶
我司科研技术团队的雄厚技术力量,使我们团队的技术一直处于业界领先水平,公司有完善的售后体系,提供全程的技术支持和售后支持,我司秉承诚信、严谨、务实、创新的科研精神,致力打造集科研咨询及实验技术于一体的服务平台,助力于您的科研工作。
订购注意事项:
► 在订购时可以适当订多一些
► 要和商家约定,没有用完的产品可以退货
► 对于产品或者不够的产品,要尽快到商家处办
► 在订购合同上注明产品的等级,防止商家以次充
► 适当地交一些定金,等到货送到家,验收无误后再付全款
► 约定产品不符合要求可无条件退货,退回定金
► 了解和落实退补货原则,现在市场上的商家对于退补货问题,都会有一些约定,多长时间内可以退货,什么样的情况可以退货,也要落实清楚。
我们的服务和业务在同行中获得一致评,得到广大科研朋友的认可,现货的物流,国内重点城市1-3天可以送达到您手中,货期2-4周,服务品质高,价格合理,种类齐全,到货迅速,我们秉承与客户共同发展的理念与您合作,欢迎咨询!
TRAK1 抗原(重组蛋白)
同酶联供应商商品:
风险提示:丁香通仅作为第三方平台,为商家信息发布提供平台空间。用户咨询产品时请注意保护个人信息及财产安全,合理判断,谨慎选购商品,商家和用户对交易行为负责。对于医疗器械类产品,请先查证核实企业经营资质和医疗器械产品注册证情况。
文献和实验抗体的结构 抗体是能与抗原特异性结合的免疫球蛋白(immunoglobulin,Ig)。Ig 分五类,即 IgG、IgA、IgM、IgD 和 IgE。与免疫测定有关的 Ig 主要为 IgG 和 IgM。Ig 由两个轻链(L)和两个重链(H)的单体组成。Ig 的轻链是相同的,有 κ(kappa)和 λ(Lambda)两种型别。五类 Ig 的重链结构不同,这决定了它们的抗原性也不同。IgG 和 IgM 的重链分别称为 γ(gamma)链和 μ(mu )链。 重链和轻链的 N 端的氨基酸排列顺序
近年来,重组蛋白的应用有了显著增长,与此同时,用于重组蛋白表达和纯化的技术和产品也得以增长。自从亲和标签融合技术出现以来,多种多样的短肽或蛋白亲和标签极大地方便了外源表达重组蛋白的分离与蛋白质复合体的纯化,已成为蛋白质研究领域不可或缺的工具。多聚组氨酸标签(His-tag)是目前高通量蛋白纯化最普遍使用的亲和标签,His 标签融合蛋白的固定化金属离子亲和层析(immobilized metal-ion affinity chromatography, IMAC)被作为主要的蛋白纯化方法。从重组蛋白
CDl 分子对脂类抗原的提呈 CDl分子在结构上与MHC I类分子相关,但Cm基因位于MHC外,无多态性。人类有五个紧密连锁的CD5基因,四个表达。编码蛋白分成两组,第一组包括CDh、CDlb和CDlc,CDld属于第二组。CDlb和CDlc提呈的脂类抗原,主要来自分枝杆菌胞壁成分,包括糖脂和磷脂等,如霉菌酸、葡萄糖单霉菌酸脂、脂阿糖甘露聚糖等。CDld分子能提呈疏水肽,也能提呈某些脂类抗原如酰基鞘氨醇。 CDlb分子存在于APC的酸性内体
技术资料